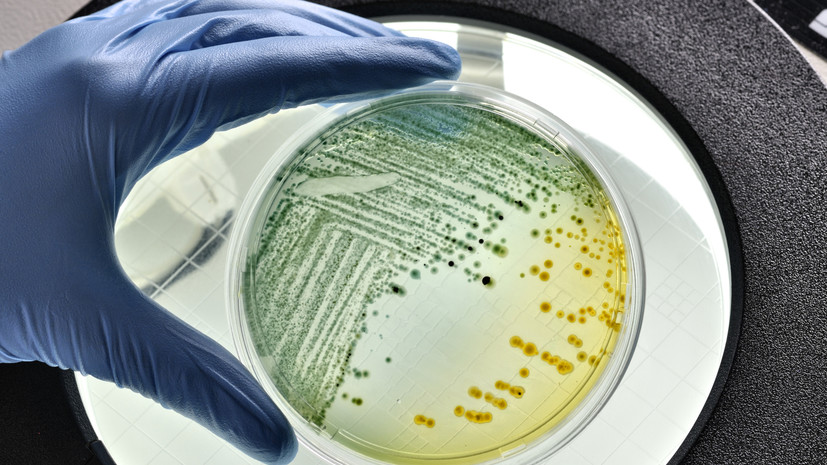
Кишечную палочку и стафилококк нашли в кафе в Калининграде, где отравились дети

Кишечную палочку и стафилококк нашли в кафе в Калининграде, где отравились дети
- Gettyimages.ru
Об этом сообщает РИА Новости.
«Только что по электронной почте мы получили результаты по продукции, которая была отобрана на испытания... неудовлетворительные результаты, выявлены бактерии кишечной палочки и стафилококк», — сказал в суде представитель Роспотребнадзора.
Ранее сообщалось, что девять школьников обратились за медицинской помощью с признаками острой кишечной инфекции после посещения кафе «Бела Дона».
21 октября стало известно, что число детей, отравившихся в кафе в Калининграде, выросло до 13.